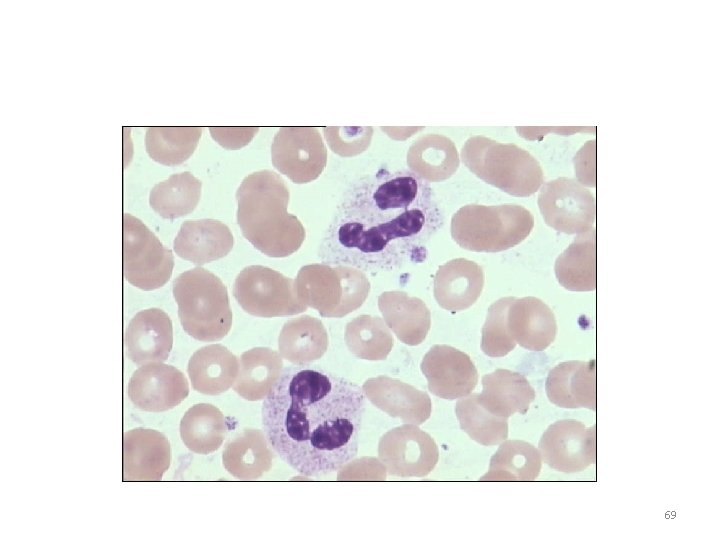
69
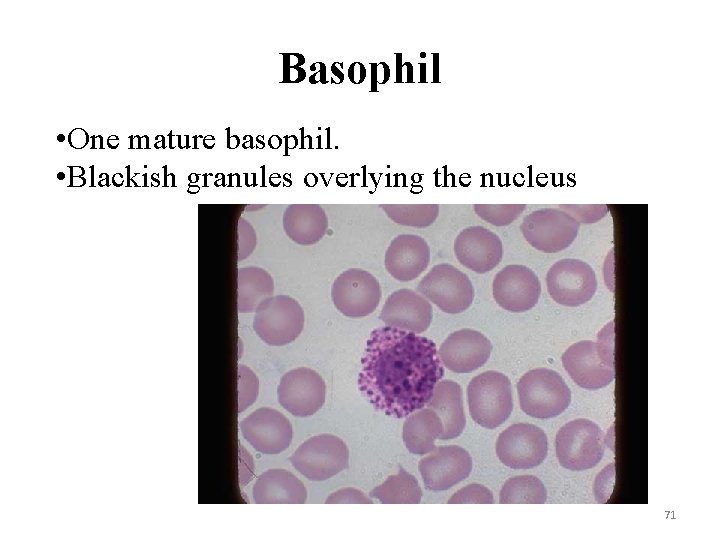
Basophil • One mature basophil. • Blackish granules overlying the nucleus 71
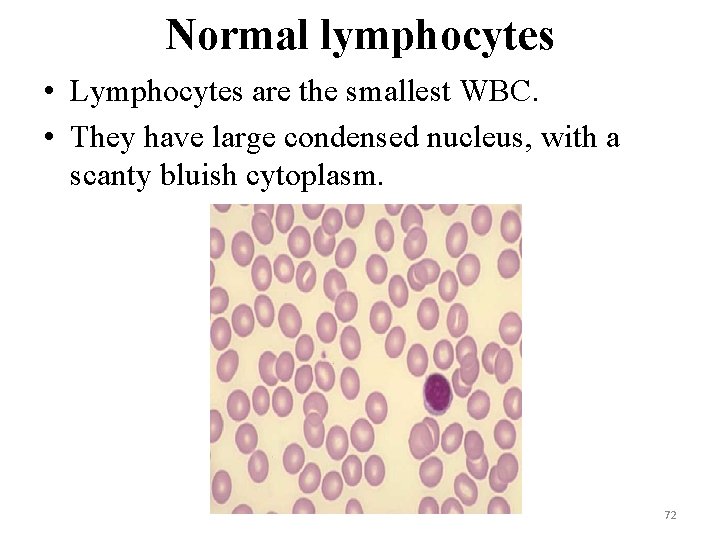
Normal lymphocytes • Lymphocytes are the smallest WBC. • They have large condensed nucleus,
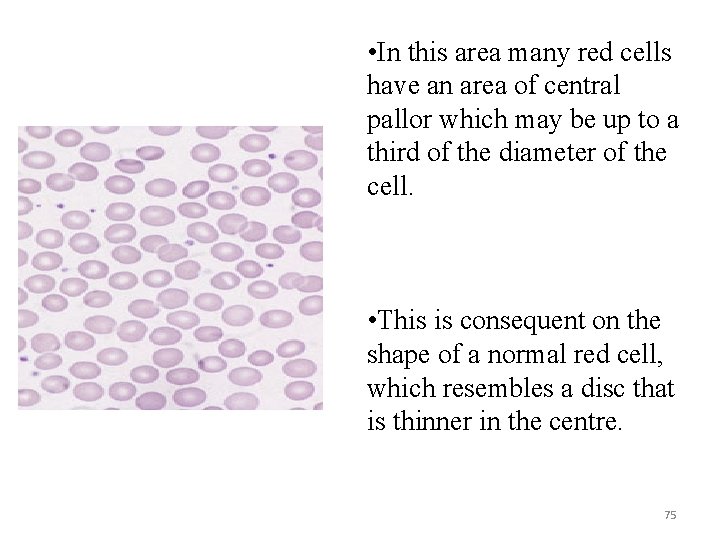
• In this area many red cells have an area of central pallor
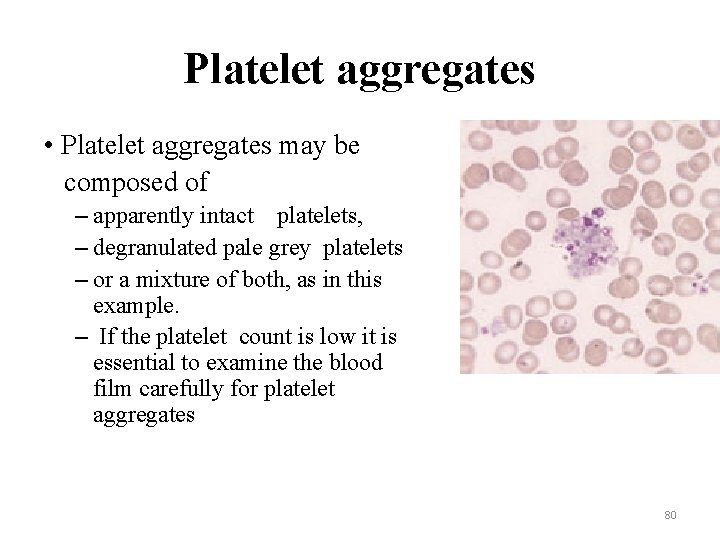
Platelet aggregates • Platelet aggregates may be composed of – apparently intact platelets, –
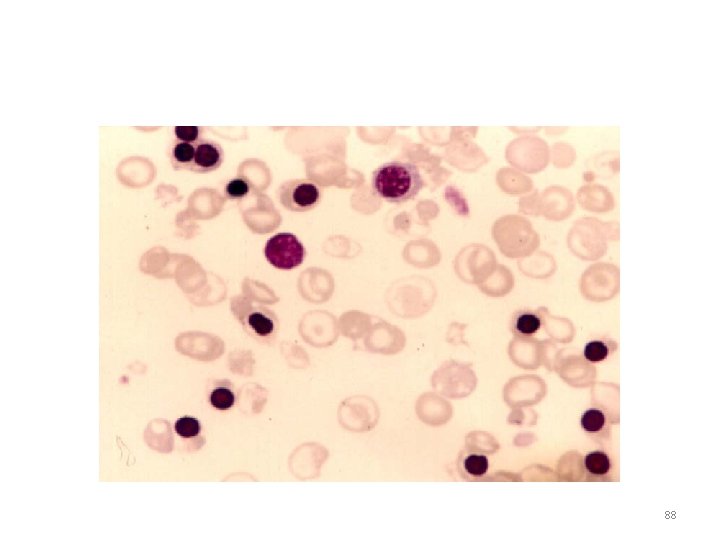
88
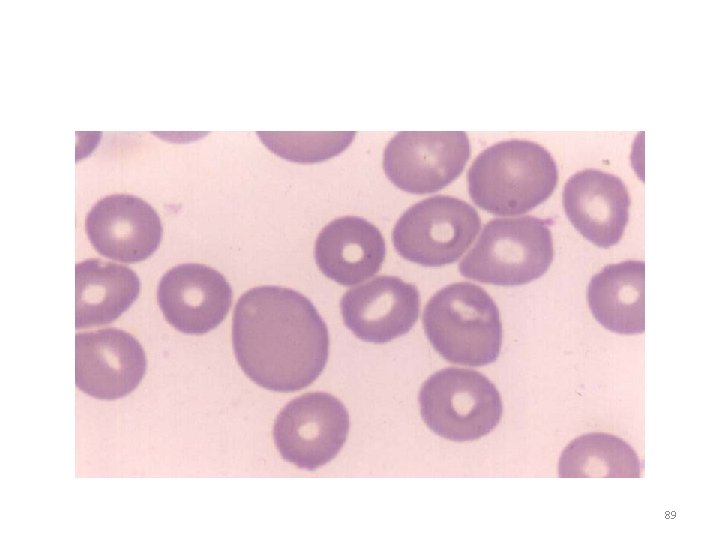
89
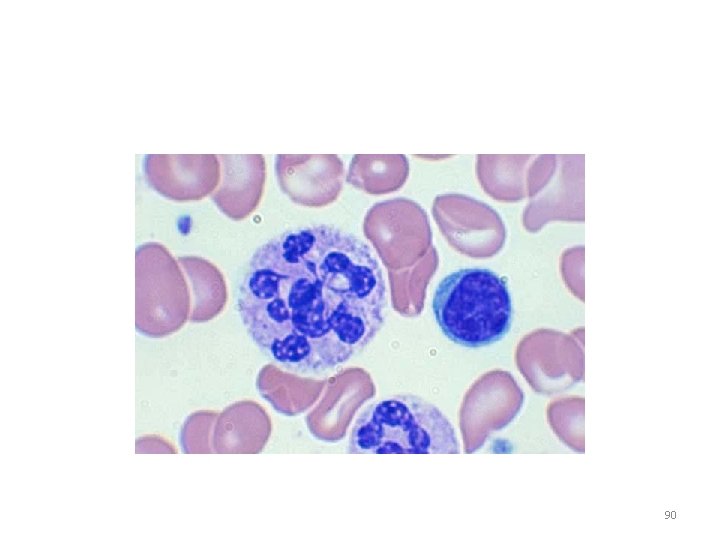
90
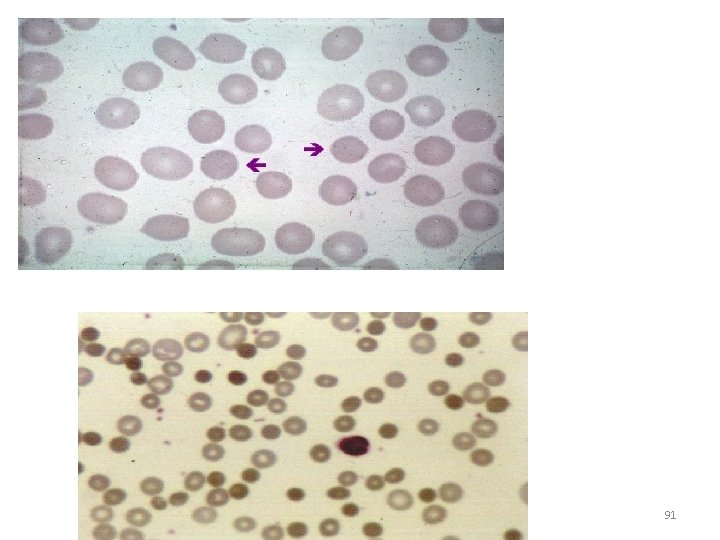
91
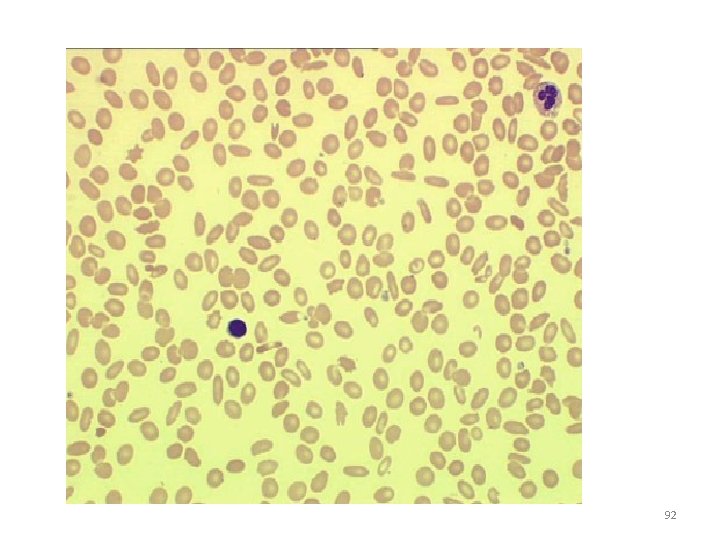
92
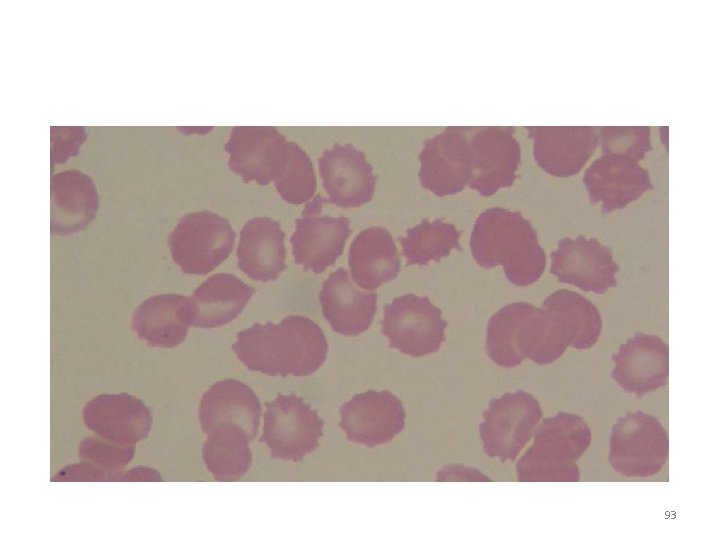
93
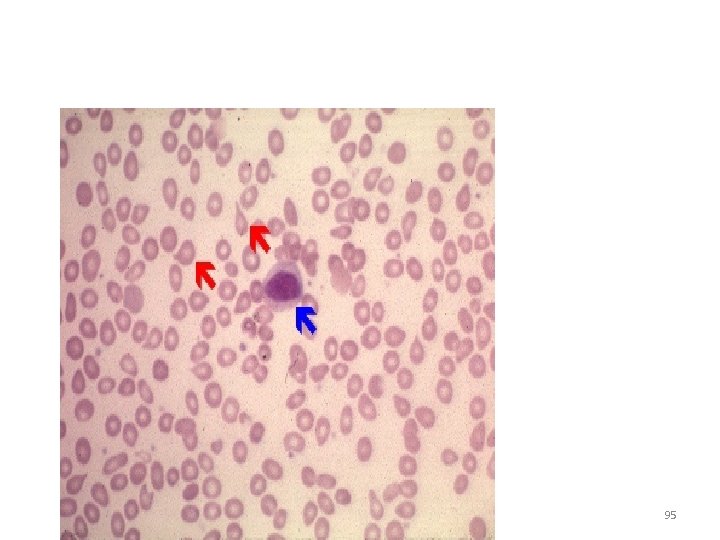
95
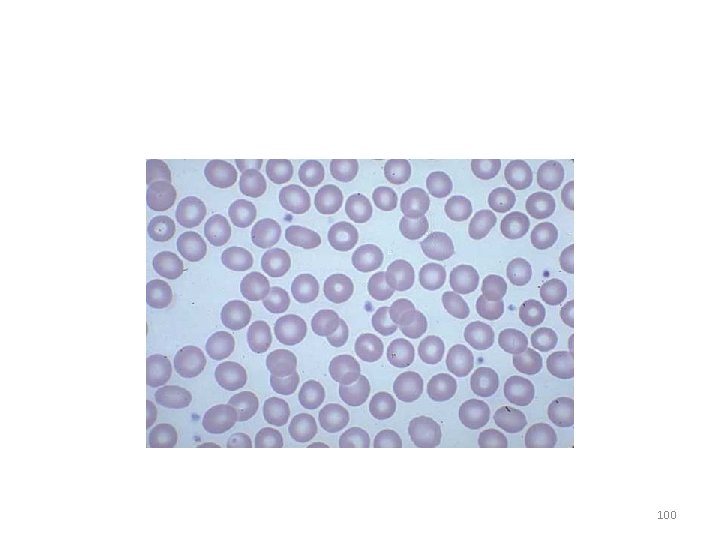
100
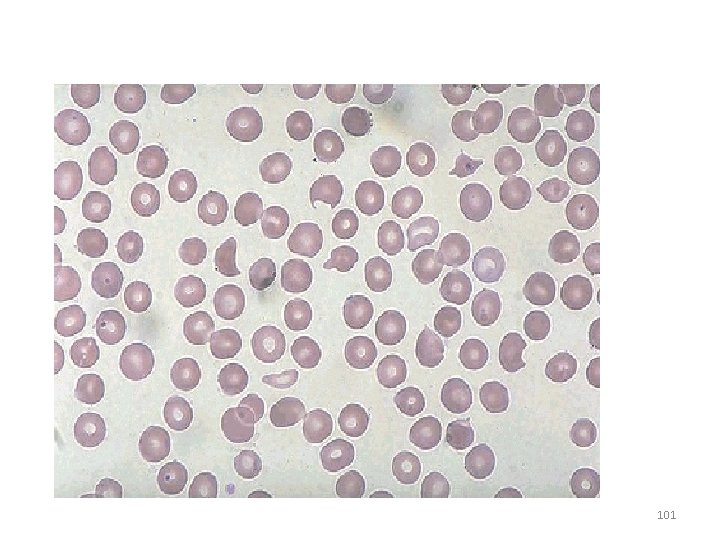
101
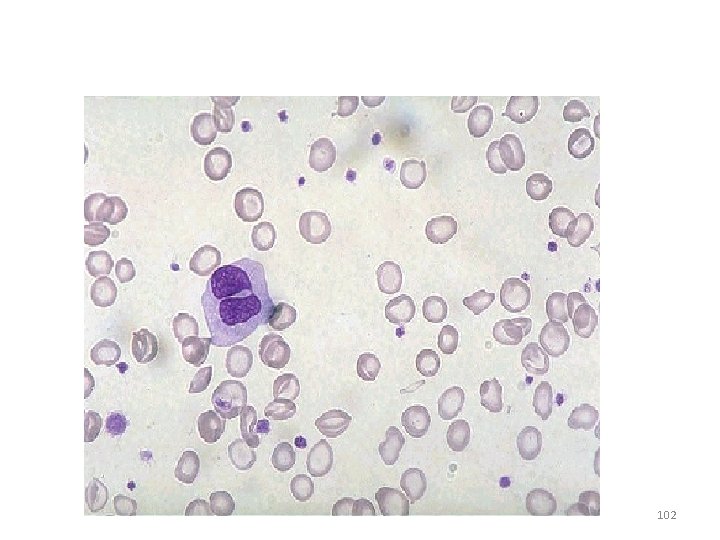
102

Examination of Peripheral Blood Smear Dr S Homathy

Examination of Peripheral Blood Smear Dr S Homathy 1

Complete blood count • The most common test used in clinical medicine • Determine type and severity of blood cell abnormalities • Nowadays, CBC is fully automated and highly reproducible. • Correct interpretation of automated CBC can reduce rate of unnecessary blood smear examination • Provide useful information for provisional diagnosis of RBC and WBC diseases 2

A well Made and well Stained Smear can provide: • Estimates of cell count • Proportions of the different types of WBC • Morphology 3

Preparation of blood smear Ø There are three types of blood smears: 1. The cover glass smear. 2. The wedge smear. 3. The spun smear. Ø The are two additional types of blood smear used for specific purposes 1. Buffy coat smear for WBCs < 1. 0× 109/L 2. Thick blood smears for blood parasites. 4

Peripheral Blood Smear • Objective 1. Specimen Collection 2. Peripheral Smear Preparation 3. Staining of Peripheral Blood Smear 4. Peripheral Smear Examination 5

Specimen Collection • Venipuncture – should be collected on an EDTA (Disodium or Tripotassium ethylene diamine tetra-acetic acid) Tube – EDTA liquid form preferred over the powdered form – Chelates calcium 6

Specimen Collection Advantages 1. Many smears can be done in just a single draw 2. Immediate preparation of the smear is not necessary 3. Prevents platelet clumping on the glass slide 7

Specimen Collection Disadvantages: PLATELET SATELLITOSIS • causes pseudothrombocytopenia and pseudoleukocytosis • Cause: Platelet specific auto antibodies that reacts best at room temperature 8

Specimen Collection • Platelet satellitosis 9

Peripheral Smear Preparation • • • Wedge technique Coverslip technique Automated Slide Making and Staining 10

Peripheral Smear Preparation Wedge technique 1. Push Type wedge preparation 2. Pull Type wedge prepartion • • Easiest to master Most convenient and most commonly used technique 11

• Material needed 1. Glass slide 3 in X 1 in 2. Beveled/chamfered edges 12

Peripheral Smear Preparation 13

Peripheral Smear Preparation • Procedures: 1. Drop 2 -3 mm blood at one end of the slide Diff safe can be used a. Easy dropping b. Uniform drop 14

Precaution: Too large drop = too thick smear Too small drop = too thin smear 15

2. The pusher slide be held securely with the dominant hand in a 3045 deg angle. - quick, swift and smooth gliding motion to the other side of the slide creating a wedge smear 16

• Control thickness of the smear by changing the angle of spreader slide • Allow the blood film to air-dry completely before staining. • Do not blow to dry. • The moisture from your breath will cause RBC artifact 17

Peripheral Smear Preparation 18

19

20

Peripheral Smear Preparation Precautions: • Ensure that the whole drop of blood is picked up and spread • Too slow a slide push will accentuate poor leukocyte distribution, larger cells are pushed at the end of the slide • Maintain an even gentle pressure on the slide • Keep the same angle all the way to the end of the smear. 21

Peripheral Smear Preparation Precautions: Angle correction: 1. In case of Polycythemia: – – high Hct angle should be lowered - ensure that the smear made is not to thick 2. Too low Hct: – Angle should be raised 22

Feature of a Well Made Wedge Smear • Smear is 2/3 or 3/4 the entire slide • Smear is finger shaped, very slightly rounded at the feathery edge: – widest area of examination • Lateral edges of the smear visible • Should not touch any edge of the slide. 23

• Should be margin free, except for point of application • Smear is smooth without irregularities, holes or streaks • When held up in light: – feathery edge should show rainbow appearance • Entire whole drop of blood is picked up and spread 24

25

26

Cover Slip Technique • rarely used • used for Bone marrow aspirate smears • Advantage: – excellent leukocyte distribution • Disadvantage: – labeling, transport, staining and storage is a problem 27

• 22 x 27 mm clean coverslip • More routinely used for bone marrow aspirate • Technique: 1. A drop of marrow aspirate is placed on top of 1 coverslip 2. Another coverslip is placed over the other allowing the aspirate to spread. 3. One is pulled over the other to create 1 thin smears 4. Mounted on a 3 x 1 inch glass slide 28

Precautions: • Very light pressure should be applied between the index finger and the thumb • Crush preparation technique • Too much pressure causes rupture of the cells making morphologic examination impossible • Too little pressure prevents the bone spicules from spreading satisfactorily on the slide 29

tail body head 30

Thin area: • Spherocytes which are really "spheroidocytes" or flattened red cells. • True spherocytes will be found in other (Good) areas of smear. 31

Thick area: • Rouleaux, which is normal in such areas. • Confirm by examining thin areas. • If true rouleaux, two-three RBC's will stick together in a "stack of coins" fashion. 32

Common causes of a poor blood smear 1. Drop of blood too large or too small. 2. Spreader slide pushed across the slide in a jerky manner. 3. Failure to keep the entire edge of the spreader slide against the slide while making the smear. 4. Failure to keep the spreader slide at a 30° angle with the slide. 5. Failure to push the spreader slide completely across the slide. 33

6. Irregular spread with ridges and long tail: Edge of spreader dirty or chipped; dusty slide 7. Holes in film: Slide contaminated with fat or grease 8. Cellular degenerative changes: delay in fixing, inadequate fixing time or methanol contaminated with water 34

Biologic causes of a poor smear 1. Cold agglutinin: – RBCs will clump together. – Warm the blood at 37° C for 5 minutes, and then remake the smear. 2. Lipemia: – holes will appear in the smear. – There is nothing you can do to correct this. 3. Rouleaux: – RBC’s will form into stacks resembling coins. There is nothing you can do to correct this 35

• Automatic Slide Making and Staining • SYSMEX 1000 i 36

Peripheral Smear Preparation • Drying of Smears – Fan – Heating pans – No breath blowing of smears – may produce crenated RBCs or develop water artifact (drying artifact) 37

Slide fixation and staining 38

Romanowsky staining Leishman's stain : a polychromatic stain • Methanol : fixes cells to slide • methylene blue stains RNA, DNA ü blue-grey color • Eosin stains hemoglobin, eosin granules ü orange-red color • p. H value of phosphate buffer is very important 39

• Pure Wright stain or Wright Giemsa stain – Blood smears and bone marrow aspirate 40

Procedure • • • Thin smear are air dried. Flood the smear with stain. Stain for 1 -5 min. Experience will indicate the optimum time. Add an equal amount of buffer solution and mix the stain by blowing an eddy in the fluid. • Leave the mixture on the slide for 10 -15 min. • Wash off by running water directly to the centre of the slide to prevent a residue of precipitated stain. • Stand slide on end, and let dry in air. 41

Features of a well-stained PBS • Macroscopically: color should be pink to purple • Microscopically: RCS: orange to salmon pink WBC: nuclei is purple to blue cytoplasm is pink to tan granules is lilac to violet Eosinophil: granules orange Basophil: granules dark blue to black 42

• 1. 2. 3. 4. Optimal Assessment Area: RBCs are uniformly and singly distributed Few RBC are touching or overlapping Normal biconcave appearance 200 to 250 RBC per 100 x OIO 43

Trouble shooting • Macroscopic 1. Overall bluer color: increased blood proteins (multiple myeloma, rouleaux formation) 2. Grainy appearance: RBC agglutination (cold hemagglutinin diseases) 3. Holes: increased lipid 4. Blue specks at the feathery edge: Increased WBC and Platelet counts 44

• • Microscopic: 10 x Objective 1. Assess overall quality of the smear i. e feathery edge, quality of the color, distributin of the cells and the lateral edges can be checked for WBC distribution 2. Snow-plow effect: more than 4 x/cells per field on the feathery edge: Reject 3. Fibrin strands: Reject 4. Rouleaux formation, large blast cell assessment 45

Too acidic Suitable Too basic 46

Ø Too Acid Stain: RBC too pale, WBC barely visible 1. insufficient staining time 2. prolonged buffering or washing 3. old stain Ø Correction: 1)lengthen staining time 2)check stain and buffer p. H 3)shorten buffering or wash time 47

Ø Too Alkaline Stain: RBC gray, WBC too dark, Eosinophil granules are gray 1. thick blood smear 2. prolonged staining 3. insufficient washing 4. alkaline p. H of stain components 5. heparinized sample Ø Correction : 1. check p. H 2. shorten stain time 3. prolong buffering time 48

Problem encountered during staining Water artifact: • moth eaten RBC, • heavily demarcated central pallor on the RBC surface, • crenation, • refractory shiny blotches on the RBC 49 49

• What contributes to the problem: 1. humidity in the air as you air dry the slides. 2. Water absorbed from the humid air into the alcohol based stain • Solution: 1. Drying the slide as quickly as possible. 2. Fix with pure anhydrous methanol before staining. 3. Use of 20% v/v methanol 50

• AUTOMATED SLIDE STAINERS 1. It takes about 5 -10 minutes to stain a batch of smears 2. Slides are just automatically dipped in the stain in the buffer and a series of rinses • Disadvantages: 1. Staining process has begun, no STAT slides can be added in the batch 2. Aqueous solutions of stains are stable only after 3 -6 hours 51

QUICK STAINS • Fast, convenient and takes about 1 minute to be accomplished • Modified Wrights-Giemsa Stain, buffer is aged distilled water • Cost effective Disadvantage: Quality of stains especially on color acceptance For small laboratories and for physician’s clinic only 52

Manual differential 53

Principle Ø White Blood Cells 1. Check for even distribution and estimate the number present (also, look for any gross abnormalities present on the smear). 2. Perform the differential count. 3. Examine for morphologic abnormalities. 54

Ø Red Blood Cells, Examine for : 1. Size and shape ( Anisocytosis, Poikilocytosis 2. Relative hemoglobin content. 3. Polychromatophilia. 4. Inclusions. 5. Rouleaux formation or agglutination Ø Platelets. 1. Estimate number present. 2. Examine for morphologic abnormalities. 55

Ø Observations Under 10 X 1. Check to see if there are good counting areas available free of ragged edges and cell clumps. 2. Check the WBC distribution over the smear. 3. Check that the slide is properly stained. 4. Check for the presence of large platelets, platelet clumps, and fibrin strands. 56

WBC estimation Under 40 X • Using the × 40 high dry with no oil. • Choose a portion of the peripheral smear where there is only slight overlapping of the RBCs. • Count 10 fields, take the total number of white cells and divide by 10. • To do a WBC estimate by taking the average number of white cells and multiplying by 2000. 57

Platelet estimation Under 100 X 1. Use the oil immersion lens estimate the number of platelets per field. 2. Look at 5 -6 fields and take an average. 3. Multiply the average by 20, 000. 4. Note any macroplatelets. 58

Ø Platelets per oil immersion field (OIF) 1)<8 platelets/OIF = decreased 2)8 to 20 platelets/OIF = adequate 3)>20 platelets/OIF = increased 59

Manual differential counts • These counts are done in the same area as WBC and platelet estimates with the red cells barely touching. • This takes place under × 100 (oil) using the zigzag method. • Count 100 WBCs including all cell lines from immature to mature. ü Reporting results • Absolute number of cells/µl = % of cell type in differential x white cell count 60

• If 10 or more nucleated RBC's (NRBC) are seen, correct the • White Count using this formula: • Corrected WBC Count = WBC x 100/( NRBC + 100) • Example : If WBC = 5000 and 10 NRBCs have been counted • Then 5, 000× 100/110 = 4545. 50 • The corrected white count is 4545. 50 61

Determine a quantitative scale 62

• Left-shift: non-segmented neutrophil > 5% – Increased bands Means acute infection, usually bacterial 63

• Right-shift: hypersegmented neutrophil • Increased hypersegmented neutrophile 64

• Leukocytosis, a WBC above 10, 000, is usually due to an increase in one of the five types of white blood cells ü Neutrophilic leukocytosisneutrophilia ü Lymphocytic leukocytosis - lymphocytosis ü Eosinophilic leukocytosis - eosinophilia ü Monocytic leukocytosis monocytosis ü Basophilic leukocytosisbasophilia 65

Morphology of WBC • Normal blood smear 66

67

Segmented neurophile • Diameter: 12 -16 • Cytoplasm : pink • Granules: primary secondary • Nucleus: dark purple blue • dense chromatin • 2 -5 lobes 68
69

Eosinophil • One eosinophil - mature. Normal blood - 100 X. • Orange colour granules. • Bi-lobed nucleus 70
Basophil • One mature basophil. • Blackish granules overlying the nucleus 71
Normal lymphocytes • Lymphocytes are the smallest WBC. • They have large condensed nucleus, with a scanty bluish cytoplasm. 72

Normal monocyte • • Monocytes are the largest WBC. The nucleus is slightly indented. The cytoplasm is abundant, sky blue in colour. Some have vacuoles in the cytoplasm. 73

Red cells • Normal red cells or erythrocytes show only slight variation in size and shape. • The blood film should be examined in the area where the red cells are touching but not often overlapping. 74
• In this area many red cells have an area of central pallor which may be up to a third of the diameter of the cell. • This is consequent on the shape of a normal red cell, which resembles a disc that is thinner in the centre. 75

Summarizing RBC Parameters • • • RBC Count )RBC x 1012/L) Hb (g/dl) Hct (5 or L/L) Mean Cell Volume (MCV. Fl) Mean Cell Hb (MCH, pg) Mean Cell Hb Concentration (MCHC. %, g/dl) 76

• RBC distribution • Morphology – – – Size Shape Inclusions Young rbcs Color Arrangement 77

Platelets • Normal platelets are also apparent. • They are small anuclear fragments between the red cells containing small purple-staining granules. 78

79
Platelet aggregates • Platelet aggregates may be composed of – apparently intact platelets, – degranulated pale grey platelets – or a mixture of both, as in this example. – If the platelet count is low it is essential to examine the blood film carefully for platelet aggregates 80

Platelet satellitism • Platelet satellitism describes the phenomenon of adherence of platelets to white cells. • It is an in vitro phenomenon of no clinical significance. • However it is important that it is detected since the platelet count will be factitiously low. 81

Staining of Peripheral Blood Smear HEMA-TEK STAINER 82

Component of automated CBC Blood count basic parameters: Hb, Hct, RBC, WBC, platlet. • Red cell indices: MCV, MCHC, RDW • WBC differentials • Cytogram or Scattergram • Reticulocyte count 83

• Red cell parameters Direct Measurement • Erythrocyte Concentration (RBC) x 106/ml • Mean Corpuscular Volume (MCV) Femtolitre (fl) • Hemoglobin (Hb) Gram/decilitre (g/dl) Indirect Measurement • Hematocrit (Hct) = RBC x MCV/10 % • Mean Corpuscular Hemoglobin (MCH) = HB x 10 / RBC (pg) • Mean Corpuscular Hemoglobin Concentration (MCHC) = Hb/Hct x 100 (g/dl) • Red Cell Distribution Width (RDW) % 84

Reticulocyte count • Reticulocyte = – non-nucleated RBC with polyribosomal RNA – as stained by supravital stain (new methylene blue or brilliant cresyl blue) • • Polychromasia underestimates Reticulocytes Three methods of reticulocyte Enumeration Manual count on slide per 1, 000 RBC Automated CBC with reticulocyte counter (Coulter VCS, Cell-Dyne 4000, Technicon-H 3) • Flow cytometry with fluorescent dyes 85

• RBC disorders Hypochromic microcytic anemia • Iron deficiency anemia • Thalassemia and hemoglobinopathy Macrocytic anemia • Megaloblastic anemia • Non-megaloblastic macrocytic anemia 86

Hemolytic anemia • Immune hemolytic anemia: AIHA, DHTR • Microangiopathic hemolytic anemia (MAHA) • Red cell enzymopathies: G-6 -PD deficiency • RBC membrane defects: spherocytosis, • ovalocytosis, elliptocytosis, stomatocytosis RBC inclusion bodies and parasites 87
88
89
90
91
92
93

94
95

96

WBC disorders Leukopenia • with absolute neutropenia: bone marrow failure, agranulocytosis • with atypical lymphocytes: viral infection, chronic lymphoproliferative disorders • with immature myeloid cells: acute leukemia, MDS or myelopthisis 97

Leukocytosis • Reactive leukocytosis: leukemoid reaction • Acute leukemia: AML vs. ALL • Chronic myeloproliferative disorders • Chronic lymphoproliferative disorders Leukoerythroblastosis 98

Platelet disorders Quantitative disorders • Isolated thrombocytopenia: Immune vs. nonimmune • Thrombocytopenia associated with other hematologic abnormalities • Thrombocytosis Qualitative disorders • Giant platelets (megathrombocytes) • Platelet inclusion or granule abnormality • Bizarre in shape and size • Megakaryocytes or megakaryoblasts 99
100
101
102
- Slides: 102